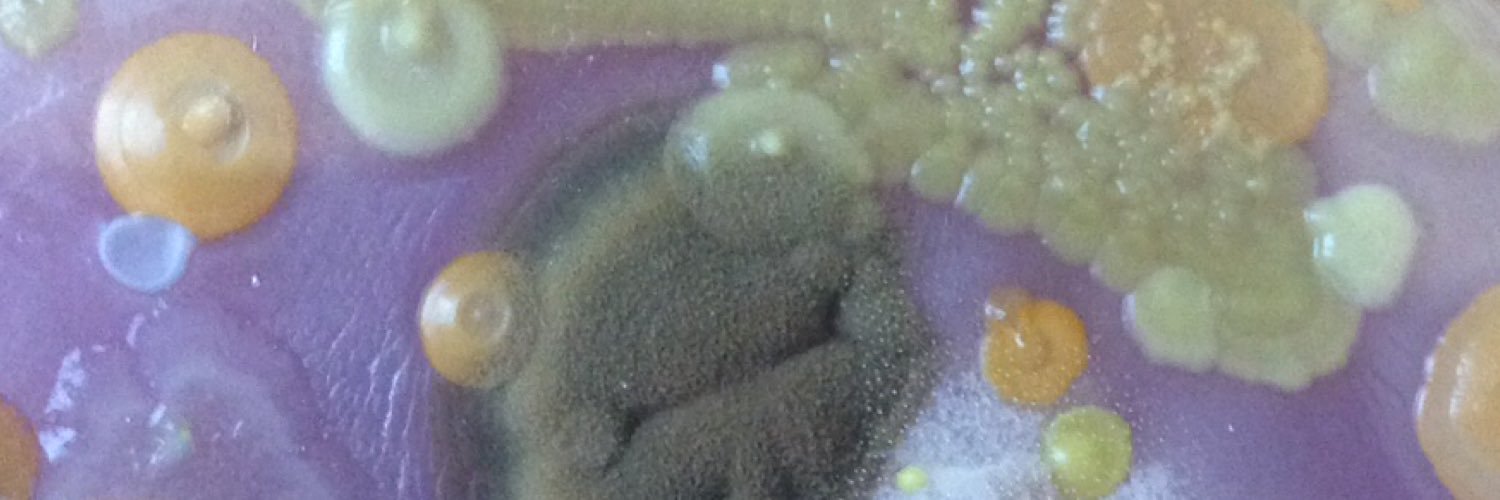
Dr Ryan George banner

Sabitlenmiş Tweet

After Ettie losing both eyes recently, I’ve learned an important lesson: we are stronger, more adaptable and more driven than we know. We will get through this, and will be stronger for it (you should see this girl chase her tennis ball). Proud to be part of @MFTnhs and @NHSuk



Salford, England 🇬🇧 English